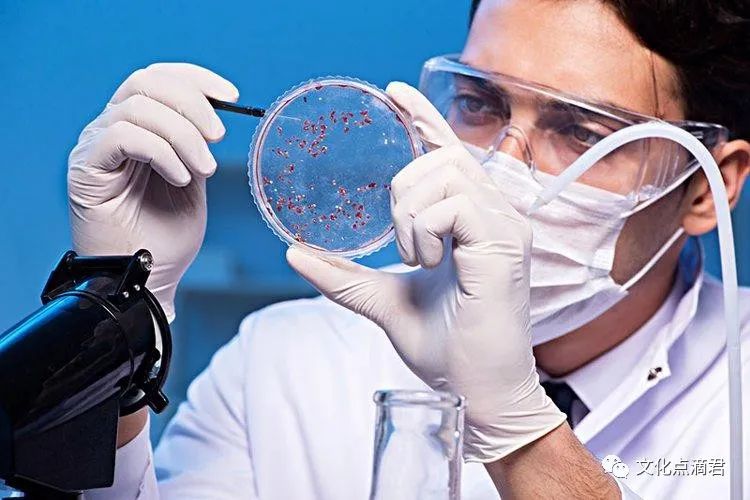

吃晚饭时,长期喝点白酒的人,身体最后会怎样?研究告诉你答案
作者:本站编辑
2023-06-14 01:22:46
44
秦大爷翘着腿,坐在院子里的藤椅上,听着戏曲,吃着花生米,喝点小酒,好不快活。可刚喝了没几口酒,儿媳妇就听到院子外传来“砰”的一声,跑过去一看,发现秦大爷躺在地上,整个人面色苍白。秦大爷晕倒后,一家人赶紧拨打120送往医院急救,但还是没有挽回他的生命。据了解,秦大爷本来就嗜酒如命,即便是查出高血压和酒精性脂肪肝,医生劝诫其戒酒,他也只是戒了一小段时间,等血压稳定后,偶然听说白酒可以预防癌症,他担心自己的脂肪肝会诱发肝癌,于是又开始每天喝2两白酒。结果没想到别说预防肝癌了,反而引起了突发性脑溢血。生活中不少老年人认为白酒可以起到抗癌作用,事实到底是怎么一回事?
一、吃饭时喝点白酒,会更健康吗?
关于酒精和癌症的关系,大家了解多少?据发表在《柳叶刀·肿瘤学》的研究发现,2020年全球大约有74万例的新发癌症因饮酒所致,其中中国约有28万例。首先酒精会经过肝脏代谢,酒精中的乙醇会在肝脏内转化成乙醛,乙醛再代谢成乙酸,最后化成水和二氧化碳,代谢过程中生成的乙醛会直接对肝脏产生毒害作用。酒精可以使肝细胞对脂肪酸的分解和代谢发生障碍,引起肝内脂肪沉积,造成酒精肝、脂肪肝。特别是高度烈酒,会使肝细胞反复发生脂肪变性、坏死和再生,引起肝脏纤维和肝硬化。最终在长期慢性炎症刺激下,肝硬化的癌变几率可达2%—4%。2020年和酒精关联的癌症就包括:食道癌、肝癌、乳腺癌、结肠癌、直肠癌、口咽癌、喉癌等。
每天身体摄入多少酒精,是可以通过公示计算:酒精摄入量=饮酒量(ml)×酒精浓度(%)×0.8。假如每天只喝2两43°的白酒(约100ml),酒精摄入量为100*0.43*0.8=34.4g。那如果每天只在吃饭时喝一点酒,会对身体有影响吗?而发表在《柳叶刀·肿瘤学》的研究结果显示,少量饮酒也能致癌,具体表现为:- 大量饮酒(>60 克/天)——导致了 34.64 万例新发癌症病例;
- 有风险的饮酒(20-60 克/天)——导致的 29.18 万例新发癌症病例;
- 适量饮酒(<20 克/天)——导致超过 10 万例新发癌症病例;
- 每天饮酒量小于 10 克,也会造成 4.13 万例新发癌症的出现。

二、38°、43°和52°的白酒,哪个伤害更高?
饮酒时,不少人可能会选择不同酒精度数的酒,那不同度数有什么差异?酒精度数,指的就是酒中纯乙醇(酒精)所含的容量百分比,例如某酒100毫升含有乙醇10毫克,那就是说这种酒是10度。现行标准白酒通行度数一般有28度、35度、38度、39度、40度、43度、48度、50度、52度、53度、68度,部分少数民族或农村自酿的白酒,度数可达75度。酒精度数相当于它对人体的“伤害值”,高度酒意味着酒精含量比较高,和低度酒相比,可以达到“一口顶三口”的效果。在同等饮酒量,酒精度数更高的,对消化系统器官伤害也越大。不论是国内还是国外,低度酒更受欢迎。据中国就业协会秘书长宋书玉介绍,中国42度以下的低度白酒占白酒消费量的50%左右。不仅是国内,国际流行的酒度大部分在43度之下。世界一些发达国家还会对进口就度数作出规定:日本要求进口酒的酒度为35度以下;美国要求不超过50度。
二、白酒不但杀菌还能抗癌?别被忽悠了
不少人认为白酒养生,其具有杀菌、抗癌作用,白酒真的和“健康”成正相关?这个说法主要来源于《酿酒科技》中一篇来自江南大学的论文提及,“白酒中发现脂肽类活性物质,具有抗病毒抗癌作用”。这些发现被酒业大力推动,白酒风头一时无二。这篇文章在白酒“活性成分”内容中阐述到,“白酒中的有机酸类、不饱和脂肪酸类、杂环类化合物和酚类化合物含量非常丰富,能够缓解酒精伤害、调节生理节奏,预防疾病和促进康复。如萜烯类化合物就具有抗癌症、抗病毒以及抗炎症等活性功效”。事实上,白酒中含有这些活性成分并不奇怪,这些活性物质广泛存在于植物中,白酒本来就是由粮食和微生物发酵,找到这类化合物很正常。
首先要明白,“活性成分”只是具有一定健康功效,但并不保证没有毒副作用;其次,动物实验、细胞实验提供的数据,并不一定能等同于人体实验。即便是成分全部有用,但在白酒中的含量也不清晰,每天喝上多少酒,才能达到效果并不肯定。因此不能只从它“含有某成分”来评判它的价值,而是需要全面评估其所有成分对健康的影响。综合考虑,酒主要成分始终是酒精,酒精是1类致癌物,它对人体致癌的作用是确凿的。
其实大部人都清楚喝酒有害,但不得不喝酒时,有什么方法能降低伤害呢?空腹时酒精吸收速度较快,对人体伤害较大,且容易醉。因此最好在喝酒前,先吃一些高脂肪、高蛋白或高碳水等食物,帮会组延缓酒精在人体的吸收时间。根据膳食指南建议,男性1天饮用酒精量不超过25克,女性不超过15克,否则视为饮酒过量。
最后提醒大家,不要乱吃所谓的“解酒药”,市面上卖的“解酒药”,都没有明确研究证明能提高乙醛脱氢酶的量或活性,无法起到真正解酒的作用。乱服药,反而会增加肝脏负担。【免责声明】:转载自其他平台或媒体的文章,本平台将注明来源及作者,但不对所包含内容的准确性、可靠性或完整性提供任何明示或暗示的保证,仅作参考。本公众号只用与学习、欣赏、不用于任何商业盈利、如有侵权,请联系本平台并提供相关书页证明,本平台将更正来源及作者或依据著作权人意见删除该文,并不承担其他任何责任。